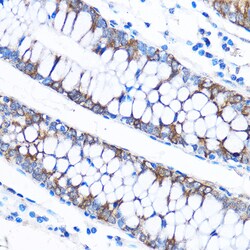

Promotional price valid on web orders only. Your contract pricing may differ. Interested in signing up for a dedicated account number?
Learn More
Learn More
Invitrogen™ CABP1 Polyclonal Antibody


Rabbit Polyclonal Antibody
Supplier: Invitrogen™ PA5116830
Description
Positive Samples: Mouse brain, Rat brain Immunogen sequence: MGGGDGAAFK RPGDGARLQR VLGLGSRREP RSLPAGGPAP RRTAPPPPGH ASAGPAAMSS HIAKSESKTS LLKAAAAAAS GGSRAPRHGP ARDPGLPSRR.
The protein encoded by this gene is a member of the S100 family of proteins containing 2 EF-hand calcium-binding motifs. S100 proteins are localized in the cytoplasm and/or nucleus of a wide range of cells, and involved in the regulation of a number of cellular processes such as cell cycle progression and differentiation. S100 genes include at least 13 members which are located as a cluster on chromosome 1q21. This protein may function in stimulation of Ca2+-dependent insulin release, stimulation of prolactin secretion, and exocytosis. Chromosomal rearrangements and altered expression of this gene have been implicated in melanoma.
Specifications
| CABP1 | |
| Polyclonal | |
| Unconjugated | |
| CABP1 | |
| Cabp1; Calbrain; calcium binding protein 1; calcium binding protein 5; calcium-binding protein 1; Caldendrin; HCALB_BR | |
| Rabbit | |
| Affinity chromatography | |
| RUO | |
| 171051, 29867, 9478 | |
| -20°C, Avoid Freeze/Thaw Cycles | |
| Liquid |
| ELISA, Immunohistochemistry (Paraffin), Western Blot | |
| 1.08 mg/mL | |
| PBS with 50% glycerol and 0.01% thimerosal; pH 7.3 | |
| O88751, Q9JLK7, Q9NZU7 | |
| CABP1 | |
| A synthetic peptide corresponding to a sequence within amino acids 1-100 of human CABP1 (NP_0010288491). | |
| 100 μL | |
| Primary | |
| Human, Mouse, Rat | |
| Antibody | |
| IgG |
Product Content Correction
Your input is important to us. Please complete this form to provide feedback related to the content on this product.
Product Title
Spot an opportunity for improvement?Share a Content Correction